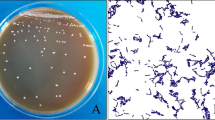

Abstract
Purpose
In the present study, we systematically identified and evaluated a synbiotic combination of phytochemical epigallocatechin gallate (EGCG) and probiotic bacteria in amelioration of immunosenescence and oxidative stress in aged mice.
Methods
Inhibitory effects of EGCG against different bacterial species were evaluated in vitro, followed by analysis to identify potential combination of EGCG and probiotic bacteria against alleviation of oxidative and inflammatory stress ex vivo. The best synbiotic combination, vis-à-vis prebiotic and probiotic supplementation alone, was then evaluated in aged Swiss albino mice for modulation of various immunological and antioxidative parameters.
Results
EGCG strongly inhibited the growth of pathogenic microbes as compared to probiotic bacteria. A combination of EGCG with probiotic Lactobacillus fermentum (LF) provided evidence of additive effects in the amelioration of oxidative and inflammatory stress-induced cell death. In vivo study revealed that combined supplementation of LF and EGCG significantly enhanced neutrophil oxidative index, CD3+ cell numbers and activation status, Th1/Th2 cytokines in splenic supernatants as well as liver Nrf-2 expression in comparison with treatments with LF or EGCG alone. The combined application of EGCG and LF did not simply result in additive or synergistic effects in relation with individual treatments.
Conclusion
These observations suggest that EGCG could be considered as a potential prebiotic that can offer second generation synbiotic health beneficial effects for the alleviation of some of the deleterious aspects of immunosenescence and aging.
Similar content being viewed by others
Avoid common mistakes on your manuscript.
Introduction
Age-associated aberrations in immune system are amongst the principal factors accountable for increased morbidity and mortality in elderly [1]. Nutritional interventions for modulation of age-related immune disorders appear a tantalizingly achievable strategy owing to well-documented anti-inflammatory and antioxidative attributes of several nutraceuticals [2]. In addition, a plethora of data has established that probiotic bacteria play a vital role in influencing not only the gut microbiome, but also different aspects of human health and behavior [3, 4]. Probiotics have traditionally been associated with small carbohydrates called prebiotics that aid in their growth and activity. However, conventional prebiotics are non-digestible carbohydrates that not only lack significant inherent bioactive properties but are also liable to encourage growth of non-probiotic bacteria such as Eubacterium biforme or Clostridium perfingens [5]. Furthermore, it has been documented that consumption of traditional prebiotics may not always induce changes in gut microbiota [6] or consistently affect clinical end points [7]. Therefore, it is increasingly desirable to identify non-carbohydrate alternatives of prebiotics with potent inherent bioactive attributes and a strong ability to differentially promote probiotic bacterial growth that may potentially confer additive or synergistic health beneficial effects on host.
A vast majority of studies pertaining to prebiotics and synbiotics in vivo have focused on gut microbiome modulation induced by supplementation of conventional prebiotics. However, a novel concept called ‘second generation synbiotics’ has been advocated recently, suggesting that prebiotics could be best defined based on their physiological effects or functional capacities in host rather than their specific microbial targets, as often viewedtraditionally [8, 9]. Synbiotics based on such prebiotics could thus confer specific and/or enhanced health beneficial effects on hosts which may not necessarily be related to microbiome modulation. In this regard, phytochemicals such as catechins represent potential prebiotic candidates, since their bioactive and pharmacological efficacies are well established. Moreover, although catechins have been generally considered as anti-bacterial agents; specific studies have also indicated that catechins differentially modulate bacterial growth with a greater inhibitory influence on pathogenic bacteria as opposed to probiotic bacteria [10,11,12]. Furthermore, there is evidence to consider that amalgamation of polyphenols with probiotic bacteria could induce enhanced health beneficial effects as reviewed by Banerjee and Dhar [13]. However, to the best of our knowledge, there are no reports assessing combined effects of probiotics and polyphenols in comparison with individual treatments on different aspects of aging and immunity. Therefore, in the present study, we hypothesized that a putative combination of green tea EGCG and probiotic bacteria could offer additive/synergistic or differential effects on various aspects of immune responses and antioxidant capacity in aging animals. To test our hypothesis, we first assessed the growth behavior of probiotic and pathogenic bacteria in the presence of EGCG. Next, we screened a potential synbiotic combination using an oxidative and inflammatory stress-based ex vivo cellular system. The identified combination was then assessed for anti-immunosenescence and immune rejuvenating effects vis-à-vis prebiotic and probiotic supplementation alone using an in vivo aging mice model. Thus, the major focus of the present investigation is to assess whether a mixture of EGCG and probiotic bacteria could significantly confer immune rejuvenating effects during aging.
Materials and methods
Microorganisms and culture conditions
Lactobacillus fermentum (LF) and Lactobacillus planatarum (LP) used in the present study were isolated from fecal matter of adult human [14, 15]. The bacteria were identified by 16 s rRNA gene sequencing and characterized for probiotic attributes as per WHO/FAO guidelines (data unpublished). These particular bacterial species were chosen in the present study after initial screening of indigenously isolated bacterial strains for potential probiotic attributes as well tolerance to EGCG (data not shown). Lactobacillus rhamnosus (ATCC 53103) was procured from HiMedia laboratories (Mumbai-India) as a probiotic standard control. The pathogenic bacteria [Escherichia coli (EC); Salmonella typhi (ST); Pseudomonas (PS); Staphylococcus aureus (SA); Klebsiella (K); Shigella flexneri (SF); Vibrio cholera (VC)] were purchased from MTCC-IMTECH, Chandigarh (India). The probiotic isolates were maintained in de Man, Rogosa and Sharpe (MRS) broth (HiMedia laboratories, Mumbai-India), while pathogens were grown in nutrient broth at 37 °C. For in vivo experiments, the bacterial cultures were stored at − 80 °C in MRS broth, which was supplemented with 25% (vol/vol) glycerol and activated before use by sub-culturing twice in MRS broth for 18 h at 37 °C.
Extraction, isolation, and identification of EGCG from Kangra tea shoots
EGCG was isolated, identified, and characterized from fresh Kangra tea shoots procured from Tea Experimental Farm, CSIR-IHBT, Palampur as described previously [16].
Effect of EGCG on bacterial growth
To assess the effect of EGCG on growth of different bacterial species, a 5% bacterial inoculum was transferred to a broth containing 0.1% EGCG (w/v) [10]. Absorbance at 600 nm was measured using Synergy H1 Multi-mode Reader microplate reader (BioTek Instruments Inc, Winooski, USA) after incubation for 24 h at 37 °C. Growth was compared to that of the control (without EGCG) for each bacterial species to determine the activity of EGCG and data are expressed as percent control growth using the formula:
Identification of EGCG–probiotic combination
The combination of EGCG and probiotic bacteria with potential health beneficial effects during aging was identified using ex vivo models of oxidative and inflammatory stress in murine peripheral blood mononuclear cells (PBMCs). PBMCs were isolated using Histopaque 1077 as previously described [16]. Briefly, whole blood (~ 1 ml) was laid over 3 ml of Histopaque 1077 and centrifuged at 400×g for 30 min at room temperature. The layer of isolated PBMCs at the interface of plasma and Histopaque solution was collected and washed twice with 5 ml PBS following which the cells were suspended in complete RPMI-1640 media for further enumeration and analysis. For induction of oxidative stress, cells were suspended in RPMI-1640 media and seeded into 6-well plates (@ 106 cells/ml) followed by incubation with tert-Butyl hydroperoxide (tBHP) at 1 mM for 3 h at 37 °C in a humidified CO2 incubator. Probiotic-conditioned media (PCM) were prepared utilizing supernatant of overnight cultured probiotic inoculum (final bacteria concentration 108 cfu/ml) in MRS broth at 37 °C. The pH of the supernatant was adjusted to 6.8–7.0, sterile filtered, and mixed with RPMI-1640 (10% v/v) to prepare final PCM. EGCG (1 µM) and PCM, alone or in combination were tested for amelioration of tBHP-induced oxidative stress by analyzing percent cell death using propidium iodide staining in AMNIS ImageStream Mark II Imaging Flow Cytometer (Merck Millipore, Germany) as described by Crowley et al. [17]. For induction of inflammatory stress, isolated PBMCs were stimulated with LPS (1 µg/ml) for 24 h at 37 °C in a humidified CO2 incubator. PCM and EGCG (1 µM) alone or in combination were tested for amelioration of LPS-induced inflammatory stress by analyzing levels of inflammatory cytokines (TNF-α/IL-6/IFN-γ) in culture supernatants using commercially available ELISA kits (eBioscience, USA) as per manufacturer’s instructions.
In vivo experiment design
Male Swiss albino mice, 16 months (weighing 38–40 g), were procured from animal house facility of Lala Lajpat Rai University of Veterinary and Animal Sciences, Hisar, India. This particular species, sex, and age group of animals were selected on the basis of our earlier profiling of age-associated immunological changes in male Swiss albino mice [18]. All animals were housed in polypropylene cages and maintained under standard laboratory conditions (12:12 h reversed light/dark cycle; relative humidity at 50–60%, temperature of 22 ± 2 °C, and adequate ventilation) at the experimental animal facility of CSIR-IHBT, Palampur. All animals were fed on commercially available pelleted mice chow (Golden feeds, New Delhi, India) and water ad libitum. Animals were randomized into four groups of six mice each: 1 control group and 3 experimental groups. Animals in the experimental groups were supplemented with either EGCG (at 100 mg/kg/animal/day) as prebiotic group (PRE) or LF at 108 cfu/ml/animal/day as probiotic group (PRO) or in combination of both PRE and PRO as synbiotic group (SYN) for 30 consecutive days by oral gavage at ~ 10:00 AM IST. EGCG was freshly prepared in PBS every day and a dose of 100 mg/kg/animal was chosen based on our previous study [16]. LF was freshly inoculated and cultured every alternate day during the experimental period and orally gavaged in PBS. Control group animals were gavaged with PBS alone to negate any effects of stress. All animal experiments were conducted with the approval and as per guidelines of the institutional animal ethics committee (approval letter no. IAEC/IHBTP1/JAN 2016; dated, 05.01.2016). At the end of experiment, animals were humanely sacrificed by CO2 asphyxiation. Blood was collected by retro-orbital puncture in EDTA coated vacutainer tubes, while spleen, liver, and small intestine of the animals were collected and processed as described below to assess various immunologic and oxidative stress parameters.
Hematological analysis
Total white blood cells and sub-populations of different leucocytes viz. neutrophils, lymphocytes, monocytes, eosinophils, and basophils were assessed in whole blood (100 µl) by automated Hematology analyzer XT 1800i (Sysmex Corporation, Japan) as per manufacturer’s guidelines.
Neutrophil isolation and respiratory burst assay
Neutrophils were isolated from whole blood by Histopaque 1077/1119 density gradient as previously described [16]. The functional capacity of neutrophils was assessed using dihydrorhodamine (DHR-123)-based respiratory burst assay kit (Cayman chemicals; Cat no. 601130) as per manufacturer’s protocol. Briefly, neutrophils at 106 cells/ml were suspended in assay buffer followed by the addition of DHR-123 and incubation in 37 °C water bath for 15 min. The cells were further incubated with or without phorbol-12-myristate-13-acetate (PMA) for 45 min at 37 °C following which cells were centrifuged and re-suspended in assay buffer and subjected to acquisition by AMNIS ImageStream Mark II Imaging Flow Cytometer (Merck Millipore, Germany). Results are expressed as oxidative index representing ratio of median fluorescence intensity of PMA stimulated versus non-stimulated neutrophils.
Labelling flow cytometric analysis in splenocytes
Splenocytes were isolated as previously described [16] and were used for immune-phenotyping in a three-color-staining experiment using flow cytometry. FITC-labelled anti-mouse CD3e, PE-labelled anti-mouse NKp46 (CD335), and vioblue-labelled anti-mouse CD69 (Miltenyi Biotec, Germany) were used for identification of cell sub-populations and activation status. NK cells were identified as CD3-NKp46+ [19, 20], while NKT cells were recognized as CD3+ NKp46+ [21]. Expression of CD69 was considered as marker of early cell activation [22]. In brief, isolated splenocytes were suspended in FACS buffer (PBS, pH: 7.4 with 0.5% BSA and 0.1% sodium azide) and incubated with diluted antibodies for 10 min in dark at 4 °C as per manufacturer’s instructions. The cells were then centrifuged at 500×g for 5 min and the supernatant was decanted. The precipitant cells were washed twice with PBS and re-suspended in FACS buffer for data acquisition. Flow cytometry was conducted using AMNIS ImageStream®X Mark II Imaging Flow Cytometer (Merck Millipore, Germany), and data were analyzed using the INSPIRE ImageStream system software. Area versus aspect ratio feature was used for identification of single circular cells and forward and side scatter profiles were used to gate on the lymphocyte population. Appropriate fluorescence minus one (FMO) controls were used in all staining to accurately identify the specific sub-population sets [16, 23].
Interleukins estimation in splenocytes
Splenocytes (106 cells/ml) were cultured in RPMI-1640 media for 24 h at 37 °C in a humidified CO2 incubator following which the cells were centrifuged and supernatant was collected for analysis of cytokines (TNF-α/IL-6/IL-10) using sandwich ELISA kits (eBioscience, USA) as per manufacturer’s instructions.
Total antioxidant capacity in plasma
Total antioxidant capacity in plasma of experimental animals was measured using antioxidant assay kit (Cayman chemicals, USA) as per manufacturer’s instructions. The assay relies on the ability of antioxidants present in sample to inhibit the oxidation of ABTS by metmyoglobin which is then compared with Trolox. Results are expressed in terms of Trolox equivalents as per manufacturer’s instructions.
Western blot analysis
Liver tissue sections (100 mg per animal) were lysed with RIPA buffer (Sigma Aldrich, US) containing protease inhibitor cocktail. Lysates were collected and centrifuged at 12,000 rpm for 20 min at 4 °C. Protein quantity was determined by Bradford assay [24]. Furthermore, 50 µg of total protein from each sample was subjected to SDS-PAGE and transferred onto polyvinylidene difuoride membrane (GE Healthcare Life Sciences, Europe,) membrane with semidry trans-blotter (BioRad, USA) at 15 V for 90 min. The membranes were blocked with 5% non-fat dried milk for 1 h at room temperature. Washed thrice in PBST and were probed with primary anti-NF-κB and anti-Nrf-2 antibodies (1:1000) (Cell Signalling Technology, USA) overnight at 4 °C with gentle shaking. The blots were again washed thrice (15 min/wash) in PBST and incubated with a 1:3000 dilution of the HRP-conjugated anti-rabbit IgG antibody (Cell Signalling Technology, USA) with gentle shaking for 1 h. Subsequently, membranes were washed and protein bands were detected using ECL substrate on Azure c300 chemiluminescent western blot imaging system. β-tubulin (Santa-Cruz, USA) expression was analyzed as a loading control. The proteinexpression relative to β-tubulin was quantified using the ImageJ software.
Statistical analyses
Data were analyzed using the GraphPad Prism (Version 6) software. Experimental results are presented as mean ± standard error of the mean (SEM) per group. Each value is the mean of the data from an assay performed in duplicate or triplicate. Data were subjected to analysis of variance (ANOVA), and the Dunnett test was used to separate the means (p < 0.05), which were considered statistically significant.
Results
Effect of EGCG on bacterial growth
As shown in Fig. 1, EGCG invariably inhibited the growth of different bacterial species, but the extent of inhibition varied greatly. All the tested pathogenic microbes showed strong growth inhibition in the presence of EGCG, while the proliferation of probiotic bacteria appeared to be least influenced by EGCG. Nevertheless, amongst the tested probiotics, the commercial strain LR was most inhibited in the presence of EGCG, while LF appeared to be least influenced. On the other hand, amongst pathogens, growth of ST appeared to be most negatively affected by EGCG, while K being the most resistant.
Effect of EGCG on growth of probiotic and pathogenic microorganisms. A 5% inoculum of each bacterial species was inoculated to a broth containing 0.1% EGCG (w/v) followed by incubation for 24 h at 37 °C. Absorbance was read at 600 nm and results are expressed as % growth with respect to control (without EGCG). Results are shown as mean ± SEM, where n = 3. Probiotic microbes: LR Lactobacillus rhamnosus, LP Lactobacillus planatarum, LF Lactobacillus fermentum, P Pediococcus pentosaceus, Pathogenic microbes: EC Escherichia coli, ST Salmonella typhi, PS Pseudomonas, SA Staphylococcus aureus, K Klebsiella, SF Shigella flexneri, VC Vibrio cholera
Identification of potential synbiotic combination
The effect of various combinations of EGCG and probiotic bacteria in amelioration of tBHP-induced cell death is presented in Fig. 2a. tBHP-induced massive cell death which was significantly reduced by EGCG. Amongst PCM of different probiotic bacteria, only LF treated cells could significantly (p < 0.05) reduce cell death by a small fraction as compared to tBHP treated cells. Similarly, combination of LF and EGCG appeared to counter cell death by 43.24% and 13.21% as compared to cells treated with tBHP and tBHP + EGCG, respectively. Thus, LF appeared to confer cytoprotective effects on cells under oxidative stress and a combination of LF and EGCG could further alleviate cell stress with a small but non-significant decrease as opposed to either EGCG or bacterial treatment alone. Similarly, an LPS-based inflammatory stress model on lymphocytes was employed to further screen for best combination of EGCG–probiotic bacteria with protective effects (Fig. 3). In general, it was observed that PCM of all probiotic bacteria were more effective in ameliorating inflammatory stress as compared to EGCG alone. Amongst the three cytokines tested, IL-6 secretion was most potently inhibited by the combination of EGCG and PCM showing statistically significant (p < 0.05) differential effects (Fig. 3b). IFN-γ levels showed that PCM of all probiotic bacteria could significantly (p < 0.05) ameliorate inflammatory stress which was unscathed by the presence of EGCG (Fig. 3c). TNF-α levels did not show any particular trend, but LF appeared to be least effective in mitigating stress-induced production of TNF-α as compared to PCM of other bacteria (Fig. 3a). Taken together, a synbiotic combination of probiotic LF and EGCG was selected for further synbiotic testing in vivo.
Identification of potential synbiotic combination with cytoprotective effects against tBHP-induced oxidative stress in murine PBMCs. Cells were exposed to tBHP (1 mM) in the presence or absence of EGCG (1 µM) or probiotic-conditioned media (10%) or both as synbiotic for 3 h at 37 °C. Probiotic bacteria used: LR Lactobacillus rhamnosus, LP Lactobacillus planatarum, LF Lactobacillus fermentum. Cell death was analyzed by flow cytometry. a Percent dead cells. b–e Representative flow cytometry images. Each column represents the mean ± SEM, where n = 3. *p < 0.05 with respect to the values of tBHP alone treated cells
Identification of potential synbiotic combination with cytoprotective effects against LPS-induced inflammatory stress in murine PBMCs. Cells were exposed to LPS (1 µg/ml) in the presence or absence of EGCG (1 µM) or probiotic-conditioned media (10%) or both as synbiotic for 24 h at 37 °C. Probiotic bacteria used: Lactobacillus rhamnosus (LR); Lactobacillus planatarum (LP); Lactobacillus fermentum (LF). Culture supernatants were used for the assessment of inflammatory molecules by sandwich ELISA. a TNF-α b IL-6 and c IFN-γ by ELISA. Each column represents the mean ± SEM, where n = 3. *p < 0.05 with respect to the values of LPS alone treated cells
Differential leukocyte count
The effect of PRE, PRO and SYN supplementation on absolute numbers of leukocyte sub-population is presented in Table 1. A statistically significant (p < 0.05) increase in percent neutrophils population was observed in SYN fed animals as compared to PRO group. An increase in neutrophil population was also observed in SYN group as compared to control group, but it could not reach statistical significance. On the other hand, a significant (p < 0.05) decrease in eosinophil population was observed in SYN group as compared to PRE group, while no significant differences in any of the remaining sub-populations groups could be throughout the study duration.
Neutrophil oxidative index
The neutrophil oxidative index recorded a statistically significant (p < 0.05) decrease in PRE and PRO groups as compared to the control group (Fig. 4a). On the other hand, SYN fed animals observed a statistically significant (p < 0.05) increase in neutrophil oxidative index as compared to control group (Fig. 4a). The effect was most distinct in SYN fed animals as compared to PRO group animals, wherein a statistically significant (p < 0.001) increase of 163% was recorded. No significant difference could be observed between PRE and PRO groups.
Effect of synbiotic supplementation on neutrophil functions. Aged animals were fed with EGCG @ 100 mg/kg/animal/day (PRE) or probiotic LF @ 108 cfu/ml/animal/day (PRO) or both as synbiotic (SYN) for 30 days. Neutrophils were isolated from blood and assessed for (a) Oxidative index. Values are means ± SEM of six animals per group. Means that do not share a common letter indicate statistical difference at p < 0.05. Representative flow cytometry plots of different treatments (b) control, (c) PRE, (d), and PRO (e) SYN
Immunophenotyping analysis
Analysis of T-cell subset populations in splenocytes by imaging flow cytometry is presented in Fig. 5. The percent T-cell population (CD3+) recorded a significant (p < 0.05) increase in PRE, PRO, and SYN groups as compared to control (Fig. 5a). However, no significant changes could be observed amongst the treatment groups (Fig. 5a). In contrast, percentage of NK cells appeared to significantly (p < 0.05) decrease in both PRE and PRO groups as compared to control group (Fig. 5b). However, no significant difference in NK cell population could be observed amongst control and SYN groups suggesting a significant (p < 0.05) increase in NK cells of SYN group when compared to PRE and PRO groups (Fig. 5b). No distinct pattern could be observed for percent NKT cells, wherein a significant (p < 0.05) increase in PRO group was observed in comparison with PRE group (Fig. 5c). No significant variations in any of the remaining groups could be observed. Analysis of cellular activation status showed that only SYN group animals had significantly (p < 0.01) increased population of activated T cells as compared to all the remaining groups (Fig. 6a). On the other hand, all the experimental groups showed significantly (p < 0.05) reduced numbers of activated NK cells as compared to control (Fig. 6b). PRO-treated group recorded highest inhibition of activated NK cells amongst different groups, while least inhibition was observed for SYN group (Fig. 6b). However, no significant variations in activation status of NKT cells could be observed amongst any tested groups (Fig. 6c). Representative flow cytometry strategy and images are presented in Supplementary Fig. 1.
Effect of synbiotic supplementation on T cells and subset population in splenocytes. Aged animals were fed with EGCG @ 100 mg/kg/animal/day (PRE) or probiotic LF @ 108 cfu/ml/animal/day (PRO) or both as synbiotic (SYN) for 30 days. T cells and sub-populations were identified using three-color flow cytometry. a % CD3+ cells, b % NK cells, c % NKT cells. Values are means ± SEM of six animals per group. Means that do not share a common letter indicate statistical difference at p < 0.05
Quantification of activation status of T cells and subsets in splenocytes. Aged animals were fed with EGCG @ 100 mg/kg/animal/day (PRE) or probiotic LF @ 108 cfu/ml/animal/day (PRO) or both as synbiotic (SYN) for 30 days. CD69 based activation status of a CD3 cells, b NK cells, and c NKT cells was evaluated using flow cytometry. Values are means ± SEM of six animals per group. Means that do not share a common letter indicate statistical difference at p < 0.05
Interleukins analysis in splenocytes
The effect of different experimental treatments on interleukins profile in cultured splenocytes is shown in Fig. 7. In general, SYN supplementation strongly enhanced the levels of all measured interleukins as compared to remaining groups. In particular, TNF-α, IL-6, and IL-10 levels showed a massive and statistically significant (p < 0.01) 33, 80, and 5.8-folds increase, respectively, in SYN group as compared to control (Fig. 7). No significant variations in PRE group as compared to control group could be observed except for IL-6 levels. The PRO-treated cells also showed strong and significant (p < 0.01) activation of Th1 cytokines (TNF-α/IL-6), while no significant changes were observed for IL-10 levels (Fig. 7). However, the ratio of TNF-α to IL-10 showed a statistically significant (p < 0.01) 5- and 68.18-folds increase in PRE and PRO fed group, respectively, as compared to control, while the ratio of IL-6 to IL-10 also observed a statistically significant (p < 0.01) increase of 32.2 and 200 folds in PRE and PRO fed groups, respectively, as compared to control (Fig. 7d). Remarkably, no statistically significant difference in either TNF-α to IL-10 or IL-6 to IL-10 ratios could be observed in SYN group as compared to control group.
Effect of synbiotic supplementation on Th1/Th2 immune response as measured by estimating interleukins in supernatants of cultured splenocytes. Aged animals were fed with EGCG @ 100 mg/kg/animal/day (PRE) or probiotic LF @ 108 cfu/ml/animal/day (PRO) or both as synbiotic (SYN) for 30 days. Interleukins were estimated by sandwich ELISA a TNF-α, b IL-6, c IL-10, and d Interleukins ratio. Values are means ± SEM of six animals per group. Means that do not share a common letter indicate statistical difference at p < 0.05
Plasma total antioxidant capacity
Analysis of total antioxidant capacity in plasma showed a robust and significant (p < 0.01) increase in PRE and SYN-treated groups as compared to control (Fig. 8). No significant difference between control and PRO could be observed. Similarly, antioxidant capacity in PRE and SYN groups were also at par with each other (Fig. 8).
Effect of synbiotic supplementation on total antioxidant capacity in plasma. Aged animals were fed with EGCG @ 100 mg/kg/animal/day (PRE) or probiotic LF @ 108 cfu/ml/animal/day (PRO) or both as synbiotic (SYN) for 30 days. Total antioxidant capacity was evaluated in terms of Trolox equivalents. Values are means ± SEM of six animals per group. Means that do not share a common letter indicate statistical difference at p < 0.05
Western blot analysis
The effect of SYN treatment on the expression of NF-κB and Nrf-2 transcription factors in liver tissue sections is presented in Fig. 9. NF-κB expression showed stark downregulation in all treated groups when compared to control suggesting anti-inflammatory effects of all treatments (Fig. 9a, c). Nrf-2 expression, on the other hand, recorded a dramatic increase in SYN fed groups only as compared to the remaining groups (Fig. 9b, d).
Western blot analysis of effect of synbiotic supplementation on transcription factors in liver cells. Aged animals were fed with EGCG @ 100 mg/kg/animal/day (PRE) or probiotic LF @ 108 cfu/ml/animal/day (PRO) or both as synbiotic (SYN) for 30 days and analyzed for the relative expression of a NF-κB and b Nrf-2. Representative western blot images of c NF-κB and d Nrf-2. Values are means ± SEM of six animals per group. Means that do not share a common letter indicate statistical difference at p < 0.05
Discussion
The objectives of the present investigation were to determine the prebiotic attributes of EGCG and its combined effect with probiotics on different compartments of immune system and antioxidant defenses in vivo. The results justify our hypothesis that SYN supplementation has pleiotropic effects on several aspects of immune system and antioxidant capacity. We observed that EGCG has the potential to differentially modulate bacterial growth with a higher inhibitory influence on pathogenic bacteria as compared to probiotics. These results are in agreement with a previous study on Kangra tea catechins by Sourabh et al. [12], wherein EGCG showed growth promoting effects on probiotics as compared to pathogens. Similarly, it has been shown that EGCG supplementation can enhance growth of commensal microbes such as Bifidobacteria and Lactobacillus along with increased concentration of short-chain fatty acids [25]. Due to their minimal inhibitory influence on probiotics, catechins have been previously suggested as prebiotics that may play an important role in the maintenance of gastrointestinal health [10]. Our results validate and corroborate these facts and we observed that probiotic LF was least sensitive to EGCG as compared to remaining tested bacteria thereby making this species a candidate for further synbiotic investigation.
In the next phase, we sought to assess second generation synbiotic attributes of EGCG that may result in specific health beneficial effects. We chose aged animals for our study, since they represent an ideal model to evaluate whether candidate nutraceuticals with proven immunomodulatory and antioxidant properties could ameliorate different aspects of aging and immunosenescence. In this regard, we and others have previously reported that catechins as well as probiotic bacteria have the potential to modulate immune responses in disease and syndromes including in aging [16, 26,27,28]. Thus, to initially screen for potential synbiotic combination(s), an inflammatory and oxidative stress-based ex vivo cellular model was chosen that aptly reflects age-associated stressors. Studies aimed at identification of probable synbiotic combinations based on their functional characterization are limited. A report by Arena et al. [29] on LPS-stimulated THP-1 macrophages has shown that mixtures of probiotic microorganisms and barley β-glucans exhibited synergistic effects in modulating the transcriptional level of several immune-related genes, leading to an overall enhanced anti-inflammatory effect. In the present study, we observed that EGCG effectively ameliorated oxidative stress, while probiotics were more potent in mitigation of inflammatory stress. However, a combination of EGCG and LF appeared to be more potent against both stress components, thereby indicating that this particular mixture of EGCG and LF could act as a candidate synbiotic. Considering this with the ability of LF to thrive in the presence of EGCG, as noted earlier, the combination of EGCG and LF was utilized for further in vivo experiments.
Analysis of in vivo study revealed that SYN supplementation to aged animals appeared to enhance both the numbers as well as the functional capacity of neutrophils as evident by a marginal increase in circulatory neutrophil population along with a stark enhancement in neutrophil oxidative index. This is of significance as we have earlier observed a compromised immune response in neutrophils of aging Swiss albino mice [18]. Our results are contrary to those reported by Roller et al. [30], wherein synbiotic supplementation of inulin with Lactobacillus rhamnosus and Bifidobacterium lactis could not influence neutrophil phagocytosis levels. It is, however, conceivable that the presence of a strong bioactive component such as EGCG and, a probiotic bacteria (LF) that tolerates EGCG, has attributed in the observed effects. The exact molecular mechanism(s) governing this phenomenon are not clear, but it is plausible to conclude that neutrophil numbers as well as functions are sensitive to SYN treatment. Flow cytometric analysis of splenocytes also indicated enhanced proliferation of T cells and its subsets in all treated animals, while remarkably, only SYN-treated animals had significantly enhanced activation (CD69) of T cells. This again highlights the significance of the synbiotic treatment and its differential effects as compared to individual treatments. A decrease in numbers as well as inefficient immune response of T cells is considered a hallmark of immunosenescence and any interventions to revert this scenario would present a major anti-immunosenescence strategy [31, 32]. In this regard, we have earlier shown that EGCG can enhance CD3+ CD8+ cells during aging [16], while probiotic bacteria have also been attributed to influence T-cell population [33]. The percentage and/or absolute number of NK cells have been reported to increase during aging as reported by several studies [34,35,36,37] which may be the result of an accumulation of long-lived NK cells in older adults [38]. In the present study, we observed that various treatments were suppressive of NK cell numbers as well as activation status, albeit with a varying degree of influence, suggesting their potency in mitigating age-associated dysfunctions in NK cells. Reports regarding the influence of aging on activation status of NK cells are conflicting. While bulk of data suggests that NK cells undergo characteristic loss of activation with aging [39]; there are also reports suggesting that gradual aging leads to over activation of NK cells, as assessed by the presence of CD69 [35]. This over activation of NK cells could contribute to age-related pathologies, especially inflamm-aging and thus, based on our observations in the present study, controlled activation of NK cells during aging may be desirable.
In the context of aging, we have previously shown that consumption of probiotic Lactobacillus fermentum fermented milk strongly enhanced pro-inflammatory cytokines with inhibition of anti-inflammatory cytokines in aging animals [26]. In the present study, analysis of the ratio of cytokines TNF-α and IL-6 to regulatory cytokine IL-10 clearly suggested that despite the observed indiscriminate increase in cytokines of SYN group; it may not have caused unwarranted activation/exacerbation of immune responses. Instead, it is reasonable to infer that SYN supplementation is capable of activating both (Th1 and Th2) cytokines, which may dynamically modulate the mechanisms of innate and adaptive immune responses by maintaining the balance between Th1 and Th2 lymphocytes [40]. Furthermore, it has been demonstrated that NF-κB transcriptional activity is up-regulated in an increased percentage of cells within a variety of tissues during aging that also contributes to the characteristic senescence associated secretory phenotype in aging cells [41]. Considering this, SYN supplementation in the present study appeared to have promoted inflammatory homeostasis by attenuating age-associated increase in liver NF-κB expression and thus would help maintain robust organ functions with age. It also signifies that despite a variety of immune stimulatory effects, SYN treatment did not result in any unwarranted systemic inflammatory exacerbation. On the other hand, expression of Nrf-2 in liver cells showed a strong up-regulation only in SYN fed animals, thereby providing further evidence of strong antioxidant defenses as well as differential effects of SYN supplementation. Nrf-2 and expression of its target antioxidant genes have been reported to decrease with age, rendering impaired adaptive response to oxidative stress [42]. It is thus not surprising that drugs that stimulate the Nrf-2 pathway are often considered for treatment of diseases that are caused by oxidative stress. Analysis of total antioxidant capacity in plasma also showed that the apparent antioxidative attributes of PRE (EGCG) supplementation are maintained during SYN supplementation thereby again indicating a functionally effective association of probiotic LF and EGCG.
Studies pertaining to systematic analysis and identification of synbiotic combinations using plant bioactive nutraceuticals and probiotics for health beneficial effects are extremely rare. A recent report has suggested that consumption of probiotic enriched with bilberry, blackcurrant, mango or rose hip attenuated early phase insulin response in healthy adults that was attributed to higher phenolic content [43]. The present work has highlighted that application of EGCG-based synbiotic combination can differentially modulate various aspects of immunosenescence and antioxidant capacity, as compared to individual treatments, thereby signifying the potential of developing functional foods based on similar approaches. Some of the limitations of our work include first the need of a deeper analyses into the observed effects. Multiple evidences in the present study have shown that SYN treatment resulted in near opposing effects on different measured parameters than PRE or PRO treatment alone. Although the exact mechanisms behind these observations are not clear; it has been reported that probiotic bacteria can metabolize polyphenols into bioactive compounds resulting in epigenetic modulations pertaining to critical cell processes [44] which may have contributed to apparent effects of SYN treatment. Second, for the in vitro experiments, the probiotic bacteria used in the present study were cultured under aerobic conditions, while in vivo, most of intestinal bacterium living in gastrointestinal tract is normally exposed to anaerobic conditions. Although there are such reports utilizing aerobic cultured Lactobacillus sp. for assessing physiological effects [45, 46]; nonetheless, it would be prudent to validate the observed efficacy of probiotic bacteria, as observed in the present study, using carefully controlled anaerobic conditions. Third, given the apparent general tendency of SYN to stimulate cellular immune response, it would also be interesting to assess such efficacy in wake of a pathogen challenge experiment in aging animals. This is of particular interest as LF treatment attenuated LPS-induced inflammatory response during ex vivo analysis but in vivo, the effects were starkly different.
In conclusion, the present work provides a novel direction to our understanding of health beneficial aspects of the mutual association of probiotics and polyphenols. Our observations provide compelling evidence that EGCG has the potential to act as a second generation synbiotic for amelioration of some of the deleterious aspects of immunosenescence and aging. However, further investigations aimed at understanding the probiotic–EGCG interactions are required to fully comprehend their apparent effects during aging.
Change history
28 June 2019
Authors of the original article have observed an inadvertent error in their manuscript post-publication.
Abbreviations
- EGCG:
-
Epigallocatechin gallate
- LF:
-
Lactobacillus fermentum
- LR:
-
Lactobacillus rhamnosus
- LP:
-
Lactobacillus planatarum
- tBHP:
-
Tert-Butyl hydroperoxide
- PRE:
-
Prebiotic
- PRO:
-
Probiotic
- SYN:
-
Synbiotic
- PBMCs:
-
Peripheral blood mononuclear cells
- PCM:
-
Probiotic-conditioned media
- NF-κB:
-
Nuclear factor kappa-light-chain enhancer of activated B cells
References
Aw D, Silva AB, Palmer DB (2007) Immunosenescence: emerging challenges for an ageing population. Immunology 120(4):435–446
Verburgh K (2015) Nutrigerontology: why we need a new scientific discipline to develop diets and guidelines to reduce the risk of aging-related diseases. Aging Cell 14(1):17–24
Sharma R, Kapila R, Kapila S (2013) Probiotics as anti-immunosenescence agents. Food Rev Int 29(2):201–216
Kerry RG, Patrab JK, Goudac S, Park Y, Shin HS, Das G (2018) Benefaction of probiotics for human health: a review. J Food Drug Anal. https://doi.org/10.1016/j.jfda.2018.01.002
Vodnar DC, Socaciu C (2012) Green tea increases the survival yield of Bifidobacteria in simulated gastrointestinal environment and during refrigerated conditions. Chem Cent J 6(1):61
Ampatzoglou A, Atwal KK, Maidens CM, Williams CL, Ross AB, Thielecke F, Jonnalagadda SS, Kennedy OB, Yaqoob P (2015) Increased whole grain consumption does not affect blood biochemistry, body composition, or gut microbiology in healthy, low-habitual whole grain consumers. J Nutr 145(2):215–221
Hollænder PL, Ross AB, Kristensen M (2015) Whole-grain and blood lipid changes in apparently healthy adults: a systematic review and meta-analysis of randomized controlled studies. Am J Clin Nutr 102(3):556–572
Bindels LB, Delzenne NM, Cani PD, Walter J (2015) Towards a more comprehensive concept for prebiotics. Nat Rev Gastroenterol Hepatol 12(5):303–310
Krumbeck JA, Maldonado-Gomez MX, Ramer-Tait AE, Hutkins RW (2016) Prebiotics and synbiotics: dietary strategies for improving gut health. Curr Opin Gastroenterol 32(2):110–119
Lee HC, Jenner AM, Low CS, Lee YK (2006) Effect of tea phenolics and their aromatic fecal bacterial metabolites on intestinal microbiota. Res Microbiol 157(9):876–884
Su P, Henriksson A, Nilsson C, Mitchell H (2008) Synergistic effect of green tea extract and probiotics on the pathogenic bacteria, Staphylococcus aureus and Streptococcus pyogenes. World J Microbiol Biotechnol 24:1837–1842
Sourabh A, Kanwar SS, Sud RG, Ghabru A, Sharma OP (2014) Influence of phenolic compounds of Kangra tea [Camellia sinensis (L) O Kuntze] on bacterial pathogens and indigenous bacterial probiotics of Western Himalayas. Braz J Microbiol 44(3):709–715
Banerjee A, Dhar P (2018) Amalgamation of polyphenols and probiotics induce health promotion. Crit Rev Food Sci Nutr. https://doi.org/10.1080/10408398.2018.1478795
Kumari M, Swarnkar MK, Kumar S, Singh AK, Gupta M (2015) Genome sequence of a potential probiotic strain, Lactobacillus fermentum HFB3, isolated from a human Gut. Genome Announc 3(6):e01296–e01315
Kumari M, Swarnkar MK, Kumar S, Singh AK, Gupta M (2015) Complete genome sequence of potential probiotic Lactobacillus sp. HFC8, isolated from human gut using PacBio SMRT sequencing. Genome Announc 3(6):e01315–e01337
Sharma R, Sharma A, Kumari A, Kulurkar PM, Raj R, Gulati A, Padwad YS (2017) Consumption of green tea epigallocatechin-3-gallate enhances systemic immune response, antioxidative capacity and HPA axis functions in aged male swiss albino mice. Biogerontology 18(3):367–382
Crowley LC, Scott AP, Marfell BJ, Boughaba JA, Chojnowski G, Waterhouse NJ (2016) Measuring cell death by propidium iodide uptake and flow cytometry. Cold Spring Harb Protoc 7:pdb.prot087163
Sharma R, Kapila R, Haq MR, Salingati V, Kapasiya M, Kapila S (2014) Age-associated aberrations in mouse cellular and humoral immune responses. Aging Clin Exp Res 26(4):353–362
Joyce JA, Pollard JW (2009) Microenvironmental regulation of metastasis. Nat Rev Cancer 9(4):239–252
Mair KH, Stadler M, Talker SC, Forberg H, Storset AK, Müllebner A, Duvigneau JC, Hammer SE, Saalmuller A, Gerner W (2016) Porcine CD3+NKp46+ lymphocytes have NK-cell characteristics and are present in increased frequencies in the lungs of influenza-infected animals. Front Immun 7:263
Pirson C, Engel R, Jones GJ, Holder T, Holst O, Vordermeier HM (2015) Highly purified mycobacterial phosphatidylinositol mannosides drive cell-mediated responses and activate NKT cells in cattle. Clin Vaccine Immunol 22(2):178–184
You J, Yaqoob P (2012) Evidence of immunomodulatory effects of a novel probiotic, Bifidobacterium longum bv. infantis CCUG 52486. FEMS Immunol Med Microbiol 66(3):353–362
Mahnke YD, Roederer M (2007) Optimizing a multicolor immunophenotyping assay. Clin Lab Med 27(3):469–485
Bradford MM (1976) A rapid and sensitive method for the quantitation of microgram quantities of protein utilizing the principle of protein-dye binding. Anal Biochem 72:248–254
Zhang X, Zhu X, Sun Y, Hu B, Sun Y, Jabbar S, Zeng X (2013) Fermentation in vitro of EGCG, GCG and EGCG3"Me isolated from Oolong tea by human intestinal microbiota. Food Res Int 54(2):1589–1595
Sharma R, Kapila R, Dass G, Kapila S (2014) Improvement in Th1/Th2 immune homeostasis, antioxidative status and resistance to pathogenic E. coli on consumption of probiotic Lactobacillus rhamnosus fermented milk in aging mice. Age (Dordr) 36(4):9686
Unno K (2016) Prevention of brain aging by green tea components: role of catechins and theanine. J Sports Med Phys Fit 5(2):117–122
Landete JM, Gaya P, Rodríguez E, Langa S, Peirotén Á, Medina M, Arqués JL (2017) Probiotic bacteria for healthier aging: immunomodulation and metabolism of phytoestrogens. Biomed Res Int. https://doi.org/10.1155/2017/5939818
Arena MP, Russo P, Capozzi V, Rascon A, Felis GE, Spano G, Fiocco D (2016) Combinations of cereal β-glucans and probiotics can enhance the anti-inflammatory activity on host cells by a synergistic effect. J Funct Foods 23:12–23
Roller M, Pietro Femia A, Caderni G, Rechkemmer G, Watzl B (2004) Intestinal immunity of rats with colon cancer is modulated by oligofructose-enriched inulin combined with Lactobacillus rhamnosus and Bifidobacterium lactis. Br J Nutr 92(6):931–938
Nikolich-Žugich J (2014) Aging of the T cell compartment in mice and humans: from no naive expectations to foggy memories. J Immunol 193(6):2622–2629. https://doi.org/10.4049/jimmunol.1401174
Jagger A, Shimojima Y, Goronzy JJ, Weyand CM (2014) Regulatory T cells and the immune aging process: a mini-review. Gerontology 60(2):130–137
Smelt MJ, de Haan BJ, Bron PA, van Swam I, Meijerink M, Wells JM, Faas MM, de Vos P (2013) Probiotics can generate FoxP3 T-cell responses in the small intestine and simultaneously inducing CD4 and CD8 T cell activation in the large intestine. PLoS One 4(7):e68952 8(
Lutz CT, Moore MB, Bradley S, Shelton BJ, Lutgendorf SK (2005) Reciprocal age related change in natural killer cell receptors for MHC class I. Mech Ageing Dev 126:722–731
Le Garff-Tavernier M, Béziat V, Decocq J, Siguret V, Gandjbakhch F, Pautas E, Debré P, Merle-Beral H, Vieillard V (2010) Human NK cells display major phenotypic and functional changes over the life span. Aging Cell 9(4):527–535. https://doi.org/10.1111/j.1474-9726.2010.00584.x
Lutz CT, Karapetyan A, Al-Attar A, Shelton BJ, Holt KJ, Tucker JH, Presnell SR (2011) Human NK cells proliferate and die in vivo more rapidly than T cells in healthy young and elderly adults. J immunol 186:4590–4598
Hazeldine J, Hampson P, Lord JM (2012) Reduced release and binding of perforin at the immunological synapse underlies the age-related decline in natural killer cell cytotoxicity. Aging Cell 11:751–759
Zhang Y, Wallace DL, de Lara CM, Ghattas H, Asquith B, Worth A, Griffin GE, Taylor GP, Tough DF, Beverley PC, Macallan DC (2007) In vivo kinetics of human natural killer cells: the effects of ageing and acute and chronic viral infection. Immunol 121:258–265
Solana R, Alonso MC, Peña J (1999) Natural killer cells in healthy aging. Exp Gerontol 34(3):435–443
Tymoshok NO, Lazarenko LM, Bubnov RV, Shynkarenko LN, Babenko LP, Mokrozub VV, Melnichenko YA, Spivak MY (2014) New aspects the regulation of immune response through balance Th1/Th2 cytokines. EPMA Journal 5(Suppl 1):A134
Tilstra JS, Clauson CL, Niedernhofer LJ, Robbins PD (2011) NF-κB in aging and disease. Aging Dis 2(6):449–465
Zhang H, Davies KJA, Forman HJ (2015) Oxidative stress response and Nrf2 signaling in aging. Free Radic Biol Med 88(Pt B):314–336
Xu J, Jönsson T, Plaza M, Håkansson Å, Antonsson M, Ahrén IL, Turner C, Spégel P, Granfeldt Y (2018) Probiotic fruit beverages with different polyphenol profiles attenuated early insulin response. Nutr J 17(1):34
Krautkramer KA, Rey FE, Denu JM (2017) Chemical signaling betweengut microbiota and host chromatin: what is your gut really saying? J Biol Chem 292(21):8582–8593
Wang Y, Liu Y, Sidhu A, Ma Z, McClain C, Feng W (2012) Lactobacillus rhamnosus GG culture supernatant ameliorates acute alcohol-induced intestinal permeability and liver injury. Am J Physiol Gastrointest Liver Physiol 303(1):G32–G41
Seenappanahalli Nanjundaiah Y, Wright DA, Baydoun AR, O’Hare WT, Ali Z, Khaled Z, Sarker MH (2016) Lactobacillus rhamnosus GG conditioned media modulates acute reactive oxygen species and nitric oxide in J774 murine macrophages. Biochem Biophys Rep 7:6:68–75
Acknowledgements
Authors acknowledge the Director, CSIR-IHBT, Palampur for supporting and providing all the necessary facilities. This work was supported by grants from the Science and Engineering Research Board, Government of India, through the Young Scientist Scheme (YSS/2015/000758) and MLP0204 of CSIR Government of India.
Author information
Authors and Affiliations
Corresponding authors
Ethics declarations
Conflict of interest
On behalf of all authors, the corresponding author states that there is no conflict of interest.
Electronic supplementary material
Below is the link to the electronic supplementary material.
Rights and permissions
About this article
Cite this article
Sharma, R., Kumari, M., Kumari, A. et al. Diet supplemented with phytochemical epigallocatechin gallate and probiotic Lactobacillus fermentum confers second generation synbiotic effects by modulating cellular immune responses and antioxidant capacity in aging mice. Eur J Nutr 58, 2943–2957 (2019). https://doi.org/10.1007/s00394-018-01890-6
Received:
Accepted:
Published:
Issue Date:
DOI: https://doi.org/10.1007/s00394-018-01890-6